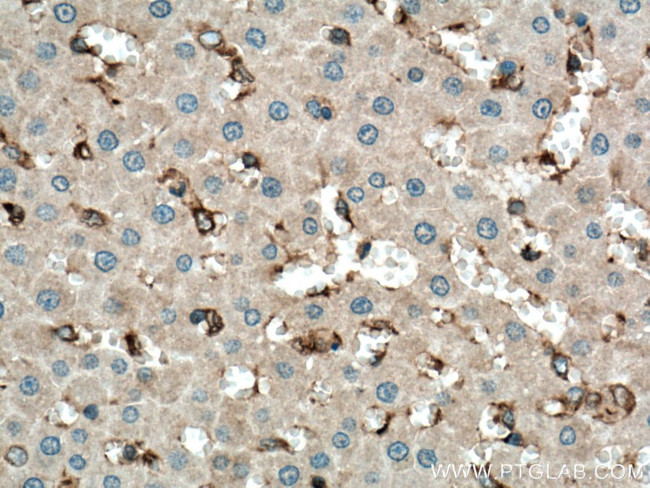
CD206 Antibody in Immunohistochemistry (Paraffin) (IHC (P))

Search
Proteintech
CD206 Polyclonal Antibody
{{$productOrderCtrl.translations['antibody.pdp.commerceCard.promotion.promotions']}}
{{$productOrderCtrl.translations['antibody.pdp.commerceCard.promotion.viewpromo']}}
{{$productOrderCtrl.translations['antibody.pdp.commerceCard.promotion.promocode']}}: {{promo.promoCode}} {{promo.promoTitle}} {{promo.promoDescription}}. {{$productOrderCtrl.translations['antibody.pdp.commerceCard.promotion.learnmore']}}






Please note: We are reviewing Western blot images included in the antibody testing data in our catalog, including those provided by third parties. Unless expressly labeled or annotated as “raw-unedited”, Western blot images included in the antibody testing data in our catalog may have been edited, optimized or otherwise adjusted for presentation.
产品信息
18704-1-AP
种属反应
已发表种属
宿主/亚型
分类
类型
抗原
偶联物
形式
浓度
规格
纯化类型
保存液
内含物
保存条件
运输条件
产品详细信息
This antibody recognizes the intracellular carboxy-terminal part of CD206 and MRC1L1.
靶标信息
CD206 (MSR, Mannose receptor, MRC1) is a 175 kDa transmembrane protein belonging to the group of pattern recognition receptors. CD206 is predominantly expressed in tissue macrophages, dendritic cells, a subpopulation of endothelial cells and sperm cells. CD206 is thought to play a role in the innate and adaptive immune response. CD206 is also expressed on microglia and mato cells of the brain but not astrocytes or neurons. CD206 also mediate the recognition and uptake of a variety of macromolecules, including modified lipoproteins, advanced glycation end (AGEs) products and amyloid b-protein (Abeta). While the normal role of CD206 is associated with cell adhesion and host defense mechanisms, it also has been implicated in the development of atherosclerosis and Amyloid beta deposition in Alzheimer's disease (AD). CD206's gene encodes the class A macrophage scavenger receptors, which include three different types (1, 2, 3) generated by alternative splicing. The isoforms type 1 and type 2 are functional receptors and are able to mediate the endocytosis of modified low density lipoproteins (LDLs). The isoform type 3 does not internalize modified LDL (acetyl-LDL) despite having the domain shown to mediate this function in the types 1 and 2 isoforms. CD206 has an altered intracellular processing and is trapped within the endoplasmic reticulum, making it unable to perform endocytosis. The isoform type 3 can inhibit the function of isoforms type 1 and type 2 when co-expressed, indicating a dominant negative effect and suggesting a mechanism for regulation of scavenger receptor activity in macrophages. Other diseases associated with CD206 dysfunction include leprosy and Gaucher's Disease.
仅用于科研。不用于诊断过程。未经明确授权不得转售。
生物信息学
蛋白别名: C-type lectin domain family 13 member D; C-type lectin domain family 13 member D-like; CD206; hMR; Human mannose receptor; Macrophage mannose receptor 1; Macrophage mannose receptor 1-like protein 1; MMR
基因别名: AW259686; CD206; CLEC13D; CLEC13DL; MR; MRC1; MRC1L1
UniProt ID: (Mouse) Q61830
Entrez Gene ID: (Mouse) 17533, (Rat) 291327